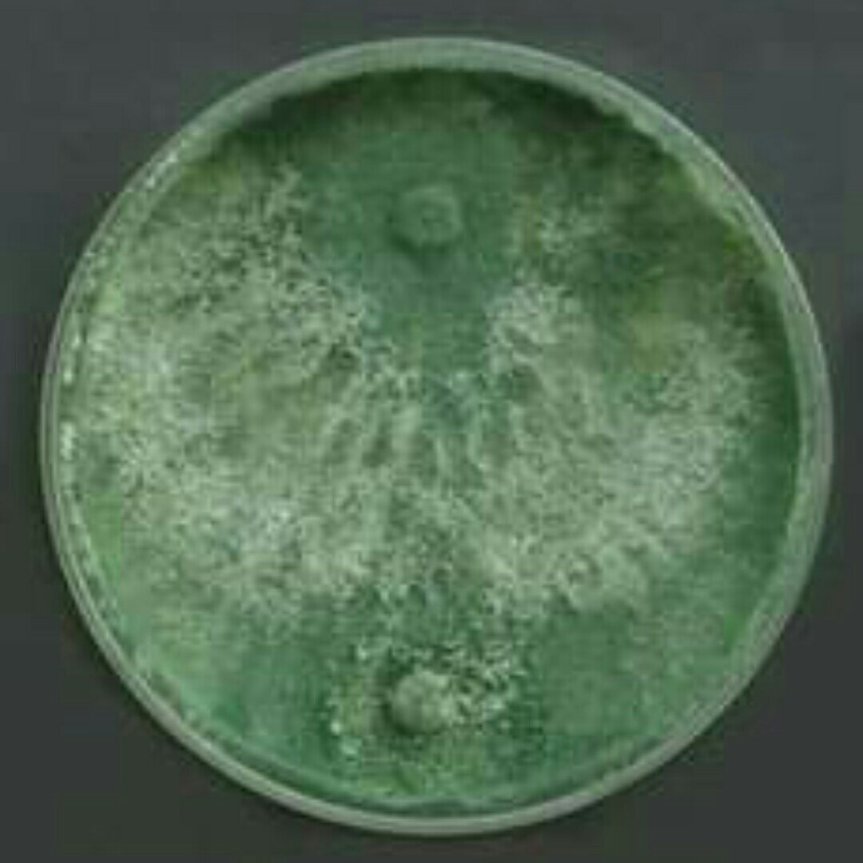

Il Trichoderma spp. è un fungo, tra i più potenti antagonisti microbici, caratterizzato da un’elevata capacità di adattamento e da una crescita molto rapida.
La presenza di Trichoderma nel terreno migliora lo stato fitosanitario della pianta e ne aumenta la resistenza alle malattie, senza eliminare gli altri microrganismi benefici.
AZIONE DIFENSIVA La principale azione del Trichoderma è l’antagonismo microbico, che avviene solitamente mediante vari meccanismi d’azione:
• micoparassitismo (il fungo produce enzimi glucanasi, cellulasi e chitinasi che degradano le pareti cellulari dell’agente patogeno, in modo da penetrare al suo interno e digerire il suo contenuto citoplasmatico); • emissione di metaboliti (produce e libera una serie di metaboliti che inibiscono la crescita e la germinazione di spore di microrganismi patogeni, influendo su determinati enzimi mediante tossicità chimica);
• antibiosi (è stata dimostrata la produzione delle cosiddette tricorzianine, che interagiscono con la membrana plasmatica dell’ospite);
• competizione (il Trichoderma si caratterizza per essere un ottimo concorrente per lo spazio e le sostanze nutrienti in situazioni sfavorevoli, che gli consentono di prevalere e colonizzare rapidamente il substrato, impedendo che si stabiliscano altri microrganismi dannosi).
Induce inoltre un incremento della produttività delle piante dovuto, tra l’altro, a un’ inattivazione dei composti tossici nella zona radicale, un incremento nell’assorbimento di sostanze nutritive e nell’efficacia dell’uso dell’azoto, come pure un aumento della solubilità delle sostanze nutrienti nel terreno.
Trichoderma ha la capacità di ostacolare lo sviluppo di molti funghi patogeni, quali: Alternaria spp., Armillaria spp, Botrytis spp., Colletotrichum spp, Fusarium spp., Phythophtora spp, Pythium spp, Rhizoctonia spp., Sclerotinia spp., Xanthomonas spp.
#trichoderma #attività #antagonismo #funzione #suolo